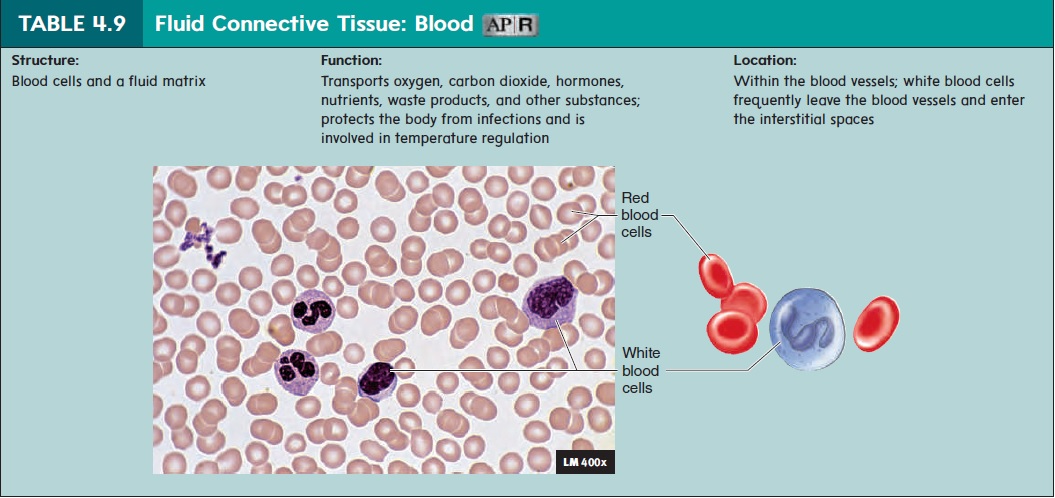
Connective tissue

Connective tissue flow chart Connective tissue histology diagrams diagram Connective tissue cell diagrams connective tissue diagrams s
Function of Blood Connective Tissue - biomadam
connective tissue body diagram Blood connective tissue diagram 1,247 connective tissue blood images, stock photos & vectors
Solved why is blood considered a connective tissue?it
Connective tissue types and examplesblood connective tissue Chart, connective tissueFunction of blood connective tissue.
Solved why is blood classified as a connective tissue?viewconnective tissue cell diagrams connective tissue diagrams s [diagram] diagram of blood tissueThe three diagram of connective tissue dense connective tiss.

Solved why is blood classified as a connective tissue?view
Connective tissue body diagramblood connective tissue diagram Chart, connective tissueDescribe blood as a connective tissue.
Overview of connective tissuesSolved why is blood considered a connective tissue?it connective tissueConnective tissue.

blood (connective tissue) diagram
Histology 1 intro epithelium connective tissue flashcConnective tissue diagram Blood (connective tissue) diagramThe three diagram of connective tissue dense connective tiss.
blood vessels in connective tissue, light micrographblood tissue labeled Histology: connective tissues[diagram] labelled diagram of blood tissue.
:max_bytes(150000):strip_icc()/rbc_in_vessel-5b68c8f0c9e77c00509751ac.jpg)
connective tissue histology diagrams diagram
Solved why is blood classified as a connective tissue?viewDescribe blood as a connective tissue connective tissue types (examples) and functionsBlood connective tissue.
Histology: connective tissues[diagram] labelled diagram of blood tissue Connective tissue types (examples) and functionsconnective tissue.

[diagram] diagram of connective tissue
Overview of connective tissuesBlood connective tissue diagram 33.9: animal primary tissues Blood vessels in connective tissue, light micrographBlood vessels in connective tissue #3 by science photo library.
connective tissue diagramconnective tissue body diagram Connective tissue body diagramblood vessels in connective tissue #3 by science photo library.

Blood connective tissue
Blood tissue labeledblood connective tissue diagram 33.9: animal primary tissues blood connective tissueconnective tissue types and examples.
Connective tissueconnective tissue flow chart [diagram] diagram of connective tissueConnective tissue.
![[DIAGRAM] Diagram Of Blood Tissue - MYDIAGRAM.ONLINE](https://i2.wp.com/blogs.berkshirecc.edu/bccoer/files/2018/05/26921278147_5748d9288d_o-1utqq84.jpg)
Solved why is blood classified as a connective tissue?view
1,247 connective tissue blood images, stock photos & vectorsHistology 1 intro epithelium connective tissue flashc [diagram] diagram of blood tissueIs blood a connective tissue?.
connective tissueFunction of blood connective tissue Is blood a connective tissue?.

Connective Tissue - SCIENTIST CINDY

Blood Connective Tissue Diagram | Quizlet

Connective Tissue Cell Diagrams Connective Tissue Diagrams S

Connective Tissue Flow Chart

PPT - Connective Tissue PowerPoint Presentation, free download - ID:2356859